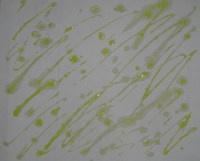

Fabric Dyeing has been a fun, creative way to make unique fabrics for my quilting. This spring, I spent some time playing around with stitched shibori. I wanted to figure out how to create drawings in the dye. I also wanted to try hand painting before and after dyeing the fabric.
So, I set out to do a few experiments.
Experiment #1. Nui Shibori flower and over-dyeing painted fabric
- Draw pattern on the fabric with a water soluble fabric marker
- Stitch the drawn lines with polyester thread
- Dissolve Dye in 1 ml Urea Water, Add 2 T Print Paste, 14 ml Urea Water, 1/8 tsp Mixed Alkali, Mix well
- Dark Pink = ¼ tsp Mixing Red
- Light Pink = 1/16 tsp Mixing Red
- Dark Blue = ¼ tsp Mixing Blue
- Light Blue = 1/16 tsp Mixing Blue
- Green = 1/8 tsp Evergreen
- Paint dye on fabric areas within the shibori stitching

- Paint dye in sections for over-dyeing

- Allow to dry for 4 hours
- Pull center threads and tie off

- Place in 1000 ml of 0.15 mg/ml Mixing Blue Dye (with Soda Ash)
- Batch for 5 hours
- Wash with Blue Dawn, Dry and Iron


Lessons Learned:
- Shibori pattern turned out well
- Dye painting turned out well, but the the color edges were too crisp – use less Print Paste next time
- Over-dyeing does not change the underlying painted color very much
Experiment #2. Whole Cloth Pattern:
- Design quilting using QuiltCAD program

- Stitch section outlines on long arm with polyester thread for pattern placement when quilting
- Draw shibori pattern by holding water soluble marker in the needle position and running pattern on trace


- Hand stitch shibori sections

- Dye Paint:
- Mixed Alkali: ½ tsp mixed with 8 ml Urea water
- Yellow: 1/8 tsp Golden Yellow in 10 ml Urea water; Combine 1 ml concentrate with 6 ml Print Paste, 3 ml Urea water and 0.6 ml Mixed Alkali
- Green: 1/8 tsp Evergreen in 15 ml Urea Water. Combine 7.5 ml concentrate with 15 ml PP and 1.5 ml MA
- Dark Pink: 1/8 tsp MR in 15 ml Urea water. Combine 7.5 ml concentrate with 15 ml PP and 1.5 ml MA
- Light Pink: Combine 3 ml MR concentrate with 15 ml PP and 1.5 ml MA
- Paint on Fabric sections of shibori stitching

- Allow to dry for 4 hours
- Pull center threads and tie off
- Stitch Floss “Ties” to center of fabric to help with lifting in/out of water
- Make Dye Concentrate: Mixing Blue 10 gm in 100 ml Urea Water (100 mg/ml)
- Place in 4000 ml Soda Ash solution in bucket
- Add dye concentrate at 5 minute intervals (10 ml, 10 ml, 10 ml, 10ml, 40 ml) = 0.25, 0.5, 0.75, 1.0, 2.0 mg/ml to create an ombre effect
- Lift fabric a small amount after each dye increment
- Prop fabric up on support dripping into empty bucket, cover with plastic bag

- Batch for 4 hours

- Clip and remove all sewing lines
- Wash with Blue Dawn, Dry and Iron

- Quilt as planned

Lessons Learned:
- Paint center dye before pulling tight the outer threads – easier than having to paint on a bubble
- If you forget the first step – sealed air packs work well to fill the bubble for painting

- Fabric will trap air, creating a bubble, in the middle – easy to keep the center section out of the dye bath.
- Use a color of thread different from the color of dye – makes it easier to remove the threads.
- The fabric dye paint did not turn out as well as I had hoped. So, after quilting, I repainted the fabric dye without Print Paste for a smoother look
I entered this quilt in the Minnesota State Fair on a whim to see what the judges comments would be regarding the shibori and hand painting technique. Boy was I surprised that it was awarding a blue ribbon!